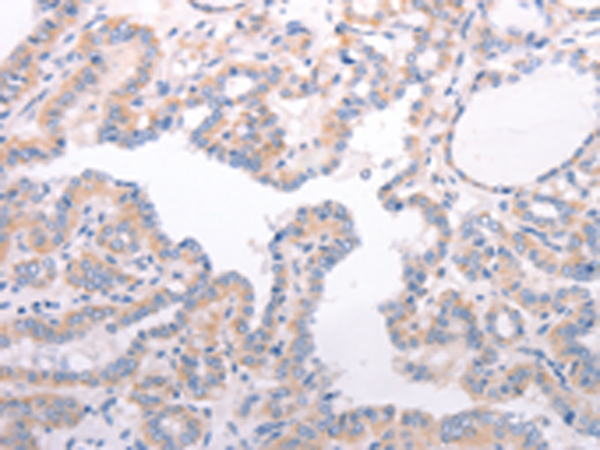
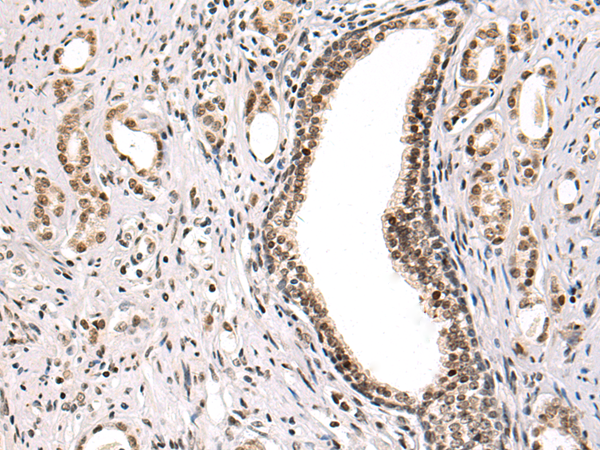

-
分类: 科研抗体货号: P00755别名: T3JAM应用: WB,IHC反应种属: Human, Mouse, Rat
-
分类: 科研抗体货号: P00646别名: R1; RR1; RIR1应用: WB,IHC反应种属: Human, Mouse
-
分类: 科研抗体货号: P00753别名: TRAP; TRAP3; MGC:45012应用: WB,IHC反应种属: Human, Mouse
-
分类: 科研抗体货号: P00715别名: IPCA7, IPCA-7, SYTVII, PCANAP7, SYT-VII应用: WB,IHC反应种属: Human, Mouse
-
分类: 科研抗体货号: P00736别名: FIX; P19; PTC; HEMB; THPH8应用: IHC反应种属: Human, Mouse, Rat
-
分类: 科研抗体货号: P00749别名: p75; TBPII; TNFBR; TNFR2; CD120b; TNFR1B; TNFR80; TNF-R75; p75TNFR; TNF-R-II应用: WB,IHC反应种属: Human
-
分类: 科研抗体货号: P00709别名: CCDC99应用: WB,IHC反应种属: Human, Mouse
-
分类: 科研抗体货号: P00734别名: SPCA应用: IHC反应种属: Human
-
分类: 科研抗体货号: P00748别名: B12; B61; EDP1; BTBD34; hBACURD2应用: WB,IHC反应种属: Human, Mouse, Rat
-
分类: 科研抗体货号: P00704别名: SP5; SP-C; PSP-C; SFTP2; SMDP2; BRICD6应用: IHC反应种属: Human

鄂公网安备42018502007531号
鄂公网安备42018502007531号

